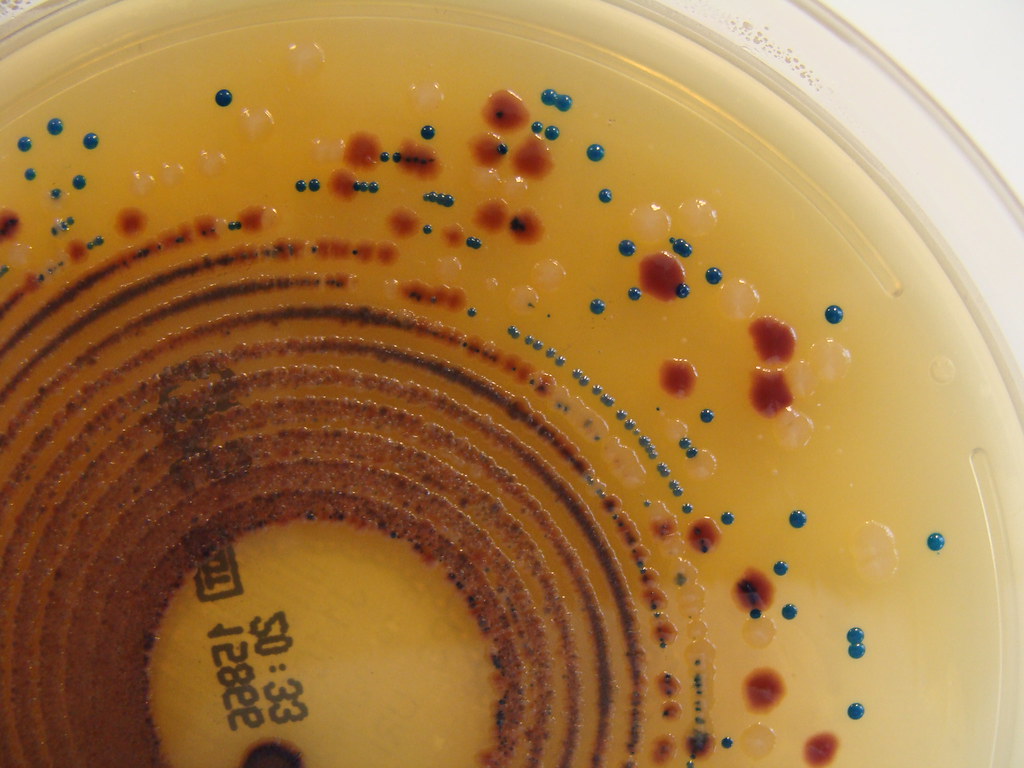
This Microbe is Spreading Antibiotic Resistance to Other Bacteria

Category: Technology & Science
-

Sandy from the Mountains Dies, Leaving a Message to the Unvaxxed
A heartbreaking reminiscence by Dr. Ricki Lewis.
-
This Microbe is Spreading Antibiotic Resistance to Other Bacteria
When good bacteria turn bad.
-

Zika Emergency Puts Open Data Policies to the Test
The Zika outbreak comes at a time of ongoing advances in data sharing policy, including a new call by the Wellcome Trust for journals and research funders to support open sharing of Zika research. PLOS Medicine Chief Editor Larry Peiperl and PLOS NTDs co-Editor-in-Chief Peter…
-

Why Do Males Fare Worse With COVID-19? A Clue From Calico Cats
Males are more likely to require intensive care and more likely to die from COVID-19. Dr Ricki Lewis considers why.
-

Antitrust Suit Against Google is a Watershed Moment
The antitrust lawsuit against Google has the potential to be the most important competition case in twenty years. Mitch Stoltz reports.
-

How the Various COVID Vaccines Work
COVID vaccine hesitancy is on the rise. Here’s how different types of vaccine actually attack the virus.
-

Waiting for a Vaccine and the Collaborative Research Alternative
America’s intellectual property laws and its jingoism are in the way of vaccine development. Dean Baker writes.
-

How COVID-19 Arose and Amplified Along the Meat Supply Chain
COVID-19 was not a surprise to anyone familiar with the ways of viruses. But a lot of folks weren’t paying attention. Ricki Lewis tells the tale.
-

Two Surgeries, 800 Years Apart
An archaeologist’s hip surgery prompts him to reimagine the experience of a Puebloan woman who survived a terrible fall centuries ago.
-

The Invisible Content Cartel That Undermines the Freedom of Expression Online
The Global Internet Forum to Counter Terrorism wants one database to rule them all, with virtually no oversight. Svea Windwehr and Jillian C. York write.